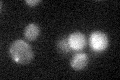
YPL052W

View description
Regulator of ornithine decarboxylase (Spe1p), antizyme that binds to Spe1p to regulate ubiquitin-independent degradation; ribosomal frameshifting during synthesis of Oaz1p and its ubiquitin-mediated degradation are both polyamine-regulated
Localization:
Intensity:
Fold change:
Significance:
-
C’ GFP library in SD

below threshold18.65 -
N' NOP1pr-GFP in SD

cytosol22.2668 -
N' TEF2pr-mCherry in SD

below threshold4.79804 -
N' NATIVEpr-GFP in SD

below threshold22.1529 -
N' TEF2pr-VC and Cyto-VN in SD

#N/A0 -
C’ GFP library in SD+DTT

cytosol17.950.96No -
C’ GFP library in SD+H2O2
cytosol21.581.15No -
C’ GFP library in Starvation Media

cytosol20.091.07No -
C’ GFP library on the background of Pup2-DaMP

N/A -
C’ GFP library on the background of CCT mutant

N/A0N/AYes
